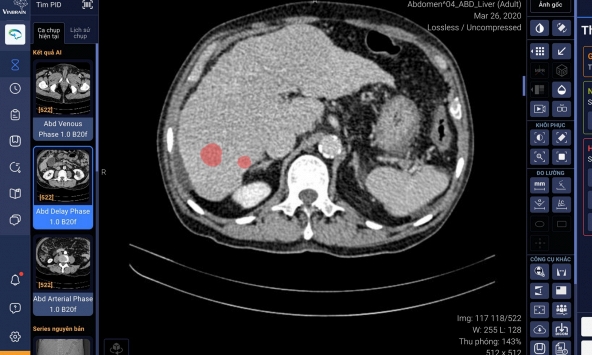
Vinbrain bắt tay Bệnh viện Đại học Y dược TP.HCM phát triển ứng dụng AI, chẩn đoán ung thư gan

Tọa đàm “Ứng dụng AI vào dạy học tiếng Anh ở Việt Nam trong bối cảnh hiện nay” do SunUni Academy (đơn vị tiên phong ứng dụng công nghệ trong đào tạo tiếng Anh trực tuyến theo chuẩn quốc tế) chủ trì và phối hợp với Báo Giáo dục & Thời đại, Ban Tổ chức học bổng E-International và Viện Đào tạo và Phát triển Kinh tế (ITED) diễn ra với sự điều hành của PGS.TS. Lê Văn Canh – Nguyên giảng viên Trường Đại học Ngoại ngữ – Đại học Quốc gia Hà Nội.
![]() |
| Toạ đàm ứng dụng AI vào dạy học tiếng Anh ở Việt Nam trong bối cảnh hiện nay |
Đây là diễn đàn học thuật chuyên sâu để các diễn giả trao đổi với công chúng tham dự về xu hướng ứng dụng công nghệ mới và chia sẻ kinh nghiệm thực tiễn hữu ích, đồng thời đề xuất các giải pháp thiết thực vào ứng dụng AI hiệu quả trong việc giảng dạy và học tiếng Anh ở Việt Nam hiện nay.
Tại Tọa đàm, các diễn giả đều đồng thuận rằng, trong thời đại 4.0, trí tuệ nhân tạo (AI) đã trở thành một trong những công cụ quan trọng trong việc đổi mới và tối ưu hóa hiệu quả hoạt động giáo dục trên toàn cầu.
Chẳng hạn như, AI có thể cá nhân hóa lộ trình học cho từng học viên dựa trên phân tích dữ liệu về năng lực và nhu cầu học tập của họ. Nhờ khả năng xử lý khối lượng thông tin khổng lồ, AI có thể đưa ra phản hồi tức thì, tự động chấm bài, cải thiện phát âm và theo dõi sự tiến bộ của học viên mà không cần sự can thiệp trực tiếp của giáo viên. Ngoài ra, việc sử dụng AI cũng có thể giúp học viên tiếp cận rất nhanh chóng những kiến thức mới mà không cần mất quá nhiều thời gian; công việc dịch thuật cũng không còn khó khăn như trước hay hỗ trợ trong việc học phát âm, viết bài luận… và rất nhiều những hoạt động khác trong quá trình học tập.
![]() |
| Các diễn giả chia sẻ quan điểm về ứng dụng của AI trong việc dạy học tiếng Anh tại Việt Nam. |
Tuy nhiên, chính sự xuất hiện và những hiệu quả đáng kinh ngạc của AI trong việc dạy và học tiếng Anh, nhiều người cũng bày tỏ lo ngại rằng liệu trong vài năm nữa, các thầy, cô giáo dạy tiếng Anh có bị thất nghiệp bởi AI không? Vai trò của đội ngũ trợ giảng, cố vấn học tập sẽ ra sao? Hình hài của mô hình lớp học tiếng Anh trực tuyến chuẩn quốc tế là như thế nào?... Và làm thế nào để ứng dụng AI một cách hiệu quả trong giáo dục?
Rõ ràng, sự thông minh và những tiến bộ không ngừng của AI đã khiến không ít ngành nghề bị "đe dọa", không chỉ riêng trong lĩnh vực học ngoại ngữ, đặc biệt với những loại hình công việc không yêu cầu tính cá nhân cao. Vậy, chúng ta cần phải làm gì để không bị thay thế bởi AI và ở giai đoạn hiện nay, có thể sử dụng AI như thế nào trong việc hỗ trợ công việc cho mình?
Tại buổi toạ đàm PGS.TS. Lê Văn Canh - Nguyên Giảng viên Trường Đại học Ngoại ngữ, Đại học Quốc gia Hà Nội cho rằng, AI sẽ thay đổi toàn diện, triệt để và định nghĩa lại toàn bộ khái niệm trong học tập. Nhờ có các công nghệ mới, lớp học không còn là nơi duy nhất để lĩnh hội kiến thức. Chất lượng giữa dạy học trực tiếp và dạy học trực tuyến không có gì khác biệt và trong tương lai, dạy học trực tuyến sẽ ngày càng phổ biến.
![]() |
| PGS.TS. Lê Văn Canh - Nguyên Giảng viên Trường Đại học Ngoại ngữ, Đại học Quốc gia Hà Nội. |
“Tuy nhiên, thứ người máy không làm được chính là thay thế xúc cảm khi giao tiếp giữa người với người, không hiểu hết được sự sáng tạo và tinh tế của ngôn ngữ. Dù tạo ra nhiều cơ hội, người máy không tạo động lực cho người học. Giáo viên mới là người tạo động lực, truyền cảm hứng, hướng dẫn học viên phương pháp học tập, phân tích thông tin” ông Lê Văn Canh nhấn mạnh.
PGS.TS. Lê Văn Canh nhận định, với những tiến bộ nhanh chóng, AI không còn là một công cụ mà sẽ là một chủ thể, một tác nhân, một thành viên trong cộng đồng, cộng tác cùng giáo viên trong hoạt động giảng dạy. Nhưng cũng không vì thế mà ta lạm dụng công nghệ, vì như thế tính sáng tạo, khả năng tư duy, phản biện sẽ bị thui chột, không thể hòa nhập hay nhìn nhận thế giới đa chiều. Chúng ta cần ưu tiên về chính sách đào tạo, hướng dẫn giáo viên phương pháp dạy học bằng công nghệ, đạo đức trong việc sử dụng và bảo vệ dữ liệu cá nhân.
![]() |
| Ông Nguyễn Tiến Nam, Chủ tịch Tập đoàn SunUni Global kiêm CEO của SunUni Academy |
Dựa trên thực tế hoạt động, ông Nguyễn Tiến Nam, Chủ tịch Tập đoàn SunUni Global kiêm CEO của SunUni Academy cho biết, trước những cơ hội và thách thức mà công nghệ AI mang lại trong thời 4.0, thay vì những lo ngại trên, SunUni Academy đã chủ trương sử dụng AI để phục vụ hiệu quả hoạt động đào tạo Anh ngữ trực tuyến. Ông cho biết: "AI rất thông minh và nhanh nhạy. Tuy nhiên, hiện nay AI vẫn chưa thể thay thế vai trò của con người bởi rõ ràng chúng ta không thể học như một cái máy. Trước sự phát triển như vũ bão của AI, cái chúng ta cần làm chính là nâng cao giá trị của bản thân và sử dụng chính AI để phục vụ cho công việc của mình".
Các chuyên gia cũng chỉ ra rằng, AI cũng đã có thể dạy học một phần nào đó, cũng có thể xây dựng những chương trình đào tạo cho người dùng. Tuy nhiên, AI có thể nắm rõ năng lực học viên nhưng không thể nắm rõ được hành vi hay cảm xúc, AI có thể xây dựng chương trình dựa trên những tổng hợp kiến thức từ internet chứ khó có thể xây dựng được chương trình mới, tư duy mới chưa từng xuất hiện. AI cũng chưa thể đi vào từng chi tiết và cách tiếp tận theo hướng cá nhân hóa. Bởi vậy, vai trò của con người vẫn là chủ đạo trong đào tạo ngoại ngữ.

An toàn thông tin mạng và ứng dụng AI trong phát triển thành phố Hà Nội thông minh
Tiên phong dẫn đầu xu hướng ứng dụng ai vào tuyển dụng, nền tảng Job3s.vn có gì?
Google ra loạt sản phẩm ứng dụng AI giữa cơn sốt ChatGPT
Vinbrain bắt tay Bệnh viện Đại học Y dược TP.HCM phát triển ứng dụng AI, chẩn đoán ung thư gan
VinBigdata công bố kết quả cuộc thi toàn cầu về ứng dụng AI trong phân tích hình ảnh y tế
Cùng chuyên mục
Cặp đôi ngôn tình trên phim yêu thắm thiết, ngoài đời không nhìn mặt nhau: Túm áo gây lộn trước cả trăm nghìn người
359 chủ phương tiện vi phạm quá tốc độ nhanh chóng nộp phạt nguội theo Nghị định 168
Ít ai ngờ: 1 loại thực phẩm để tủ lạnh lại tốt cho đường huyết hơn lúc mới mua, lợi cả tiêu hoá
Hiện tượng lạ khiến nhiều hộ dân hoang mang: Công an vào cuộc, phát hiện vật thể không rõ nguồn gốc
Rượu bia chỉ xếp thứ 5: Đây mới là "thủ phạm" đầu bảng bào mòn sức khỏe đàn ông nhanh nhất
Sự hết thời của mỹ nhân có gương mặt đẹp nhất showbiz: Giải nghệ rồi cạo đầu gây sốc, làm 1 điều cả triệu người dậy sóng